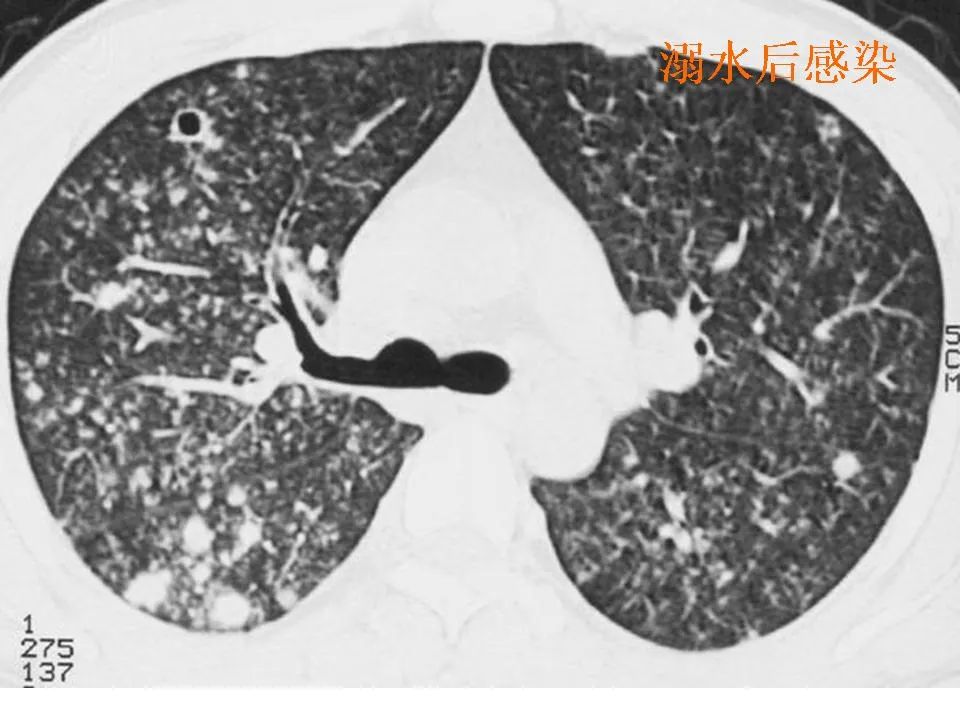
细支气管肺泡癌的影像学_李惠民

肺泡癌

细支气管肺泡癌的影像学_李惠民
图片尺寸960x720
细支气管肺泡癌的影像学_李惠民
图片尺寸960x720
弥漫型细支气管肺泡癌化疗有效1例并文献复习
图片尺寸709x546
弥漫型细支气管肺泡癌化疗有效1例并文献复习
图片尺寸731x550
弥漫性细支气管肺泡癌(bac)
图片尺寸287x229
细支气管肺泡癌的影像学_李惠民
图片尺寸960x720看图说肺囊泡性肺癌
图片尺寸700x676【实用图文】肺泡癌的影响诊断
图片尺寸1199x899
细支气管肺泡癌
图片尺寸571x800
肺泡癌
图片尺寸1080x810
细支气管肺泡癌的影像学_李惠民
图片尺寸960x720
第三节 肺泡肺癌
图片尺寸759x814
肺大泡
图片尺寸500x532
肺大泡
图片尺寸500x308![【影像读片】影像读片 肺泡细胞癌?结节病?抑或其它 [病例帖]](https://i.ecywang.com/upload/1/img0.baidu.com/it/u=3651163542,2620240397&fm=253&fmt=auto&app=138&f=JPEG?w=500&h=343)
【影像读片】影像读片 肺泡细胞癌?结节病?抑或其它 [病例帖]
图片尺寸2480x1700细支气管肺泡癌的影像学
图片尺寸960x720
细支气管肺泡癌的影像学_李惠民
图片尺寸960x720
肺泡癌影像诊断与鉴别诊断
图片尺寸622x383
病例五:反复发热,咳嗽伴气促(结果15楼:肺泡癌)
图片尺寸1198x916
肺泡癌影像诊断与鉴别诊断
图片尺寸1048x485

.png)
.png)









![【影像读片】影像读片 肺泡细胞癌?结节病?抑或其它 [病例帖]](https://img.dxycdn.com/upload/2009/11/20/16689047.jpg)




